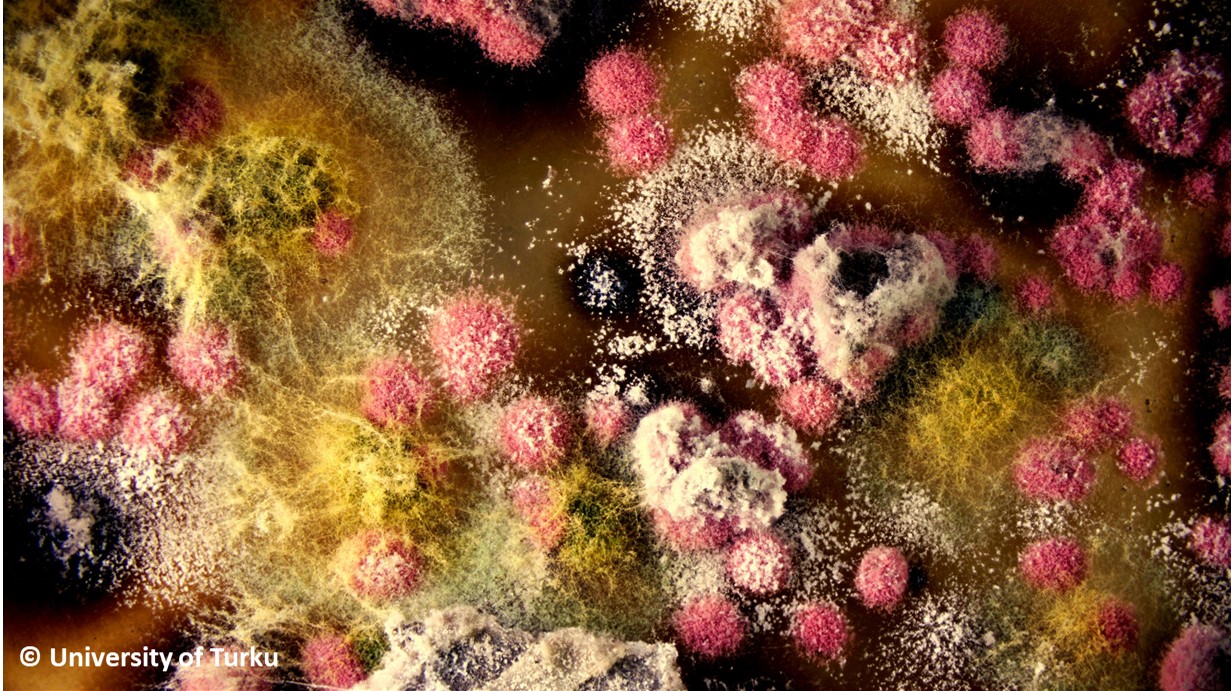
ASTEvertailu

Test details
When adding a new registration, please add your personal mobile phone number into the "Additional information" field of the Billing details. Check also the validity of your contact details form the "Customer information" page - Thank you!
ASTE 04/2026 - Mikrobiological housing health analyses
Proftest Syke will organize a proficiency test in cooperation with the Aerobiology Laboratory of the Department of the Biodiversity Sciences, University of Turku for the laboratories conducting housing health analyses. Following samples will be provided in the PT: building material as well as suspension samples for dilution cultivation method, samples of pure cultures for identification, and building material samples for direct cultivation as well as for qPCR method for detection of microbial growth, and microscopical photographs of building material to detect fungal mycelia (mimicking direct microscopy of samples).
About 15 laboratories are expected to participate in this proficiency test. The organizing of this proficiency test is not included in the accreditation scope of Proftest Syke (finas.fi/sites/en), however, its organization follows the principles of accredited operations..
Registration is open until 18 March 2026.
Sample delivery weeks 16 and 17/2026.
The final report for the proficiency test will be published in September 2026
Sample delivery weeks 16 and 17/2026.
The final report for the proficiency test will be published in September 2026
